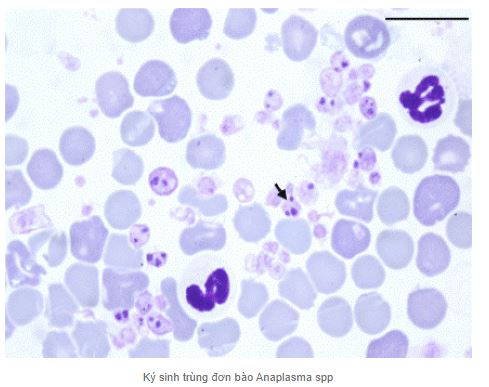

TÌM HIỂU VỀ BÊNH BIÊN TRÙNG TRÊN BÒ
Bênh Biên Trùng Trên Bò là một trong những bệnh ký sinh trùng đường máu phổ biến ở bò, đặc biệt là bò sữa nhập nội, bệnh do đơn bào ký sinh trong hồng cầu bò gây ra. Đơn bào có thể tồn tại trong máu nhiều năm. Bệnh lây lan chủ yếu qua vật chủ trung gian là ve hút máu từ bò bị bệnh rồi truyền sang cho bò khỏe.
𝟭. 𝗧𝗶̀𝗻𝗵 𝗵𝗶̀𝗻𝗵
- Bệnh biên trùng bò phân bố rộng ở khắp nơi trên thế giới; Bệnh thường nặng và thấy nhiều ở các nước nhiệt đới.
- Ở Việt Nam, bệnh phổ biến trên đàn bò sữa; tỷ lệ nhiễm ký sinh trùng từ 5 – 8%; bệnh gây nhiều thiệt hại cho đàn bò sữa nhập nội.
𝟮. 𝗡𝗴𝘂𝘆𝗲̂𝗻 𝗻𝗵𝗮̂𝗻
- Ở Việt Nam đã thấy 2 loài biên trùng gây bệnh cho bò:
- Loài Anaplasma marginale: hình cầu, nhỏ; ký sinh ở rìa hồng cầu; 01 hồng cầu có 1-5 biên trùng; loài này rất phổ biến.
- Loài Anaplasma centrale: ký sinh ở gần trung tâm và trung tâm của hồng cầu; loài này ít gặp
𝟯. 𝗕𝗲̣̂𝗻𝗵 𝗹𝘆́
- Biên trùng ký sinh trong hồng cầu làm biến dạng hồng cầu, giảm tuổi thọ của hồng cầu.
- Độc tố biên trùng tiết vào máu gây rối loạn điều hoà nhiệt; phá huỷ hồng cầu, ức chế cơ quan tạo máu của bò bệnh, dẫn đến thiếu máu và suy nhợc, giảm lượng sữa.
𝟰. 𝗧𝗿𝗶𝗲̣̂𝘂 𝗰𝗵𝘂̛́𝗻𝗴
- Thời kỳ ủ bệnh của bò: 6 – 12 ngày.
- Sốt cao 40-41,70C; ít ăn hoặc bỏ ăn; nằm bệt.
- Không có nớc tiểu đỏ, vì mức độ tan vỡ hồng cầu ít hơn nhiều so với tác hại của lê dạng trùng.
- Bò thở khó, di chuyển khó khăn.
- Thiếu máu và suy nhợc, vật bệnh chết do kiệt sức sau 7-10 ngày bị bệnh thể cấp tính và sau 3 – 6 tháng bị bệnh thể mãn tính.
𝟱. 𝗕𝗲̣̂𝗻𝗵 𝘁𝗶́𝗰𝗵
Niêm mạc và thịt nhợt nhạt do thiếu máu.Túi mật cằng vì dịch mật ứ trệ, không lu thông.
𝟲. 𝗗𝗶̣𝗰𝗵 𝘁𝗲̂̃
- Bò bị bệnh ở tất cả các lứa tuổi. Bò sữa nhập nội thờng bị bệnh cấp tính; bò nội bị bệnh mãn tính hoặc mang trùng.
* Vật chủ trung gian gồm 2 nhóm:
- Côn trùng môi giới: Ruồi hút máu (Stomoxy dinae) và mòng (Tabanidae).
- Vật chủ trung gian: Các loài ve cứng (Ixodidae) trong côn trùng, biên trùng phát triển một số giai đoạn trong vòng đời.
𝟳. 𝗖𝗵𝗮̂̉𝗻 đ𝗼𝗮́𝗻
- Chẩn đoán lâm sàng: Căn cứ vào các dấu hiệu lâm sàng đặc trưng: sốt cao, bần huyết, không có huyết sắc tố trong nước tiểu.
- Chẩn đoán phòng thí nghiệm: làm tiêu bản máu khô, đàn mỏng, nhuộm Giemsa, kiểm tra dưới kính hiển vi tìm biên trùng.
- Chẩn đoán miễn dịch: áp dụng phơng pháp Card – Test và miễn dịch men (ELISA) để phát hiện kháng thể trong máu bò bệnh
𝟴. 𝗣𝗵𝗼̀𝗻𝗴 𝗯𝗲̣̂𝗻𝗵
- Tiêu diệt ruồi, mòng, ve hút máu và truyền bệnh, chuồng trại phải có tấm che chống ruồi mộng. Phát quang bờ bụi và bãi chăn để côn trùng không thể cư trú và phát triển được. Phun thuốc diệt côn trùng ở quanh chuồng trại theo định kỳ 1 tháng/lần.
- Chăm sóc, nuôi dưỡng và sử dụng hợp lý để tăng sức đề kháng cho vật nuôi.
- Định kỳ dùng thuốc khử trùng tiêu độc: Han-Iodine 10%: 1 lít pha với 100 lít nước sạch, phun trong ngoài chuồng trại. Thực hiện 1 – 2 lần/tuần; Hantox-200: lọ 50 ml pha 5 lít nước phun diệt côn trùng ruồi, muỗi, mòng 2 – 3 tuần/lần.
- Tăng cường nuôi dưỡng và chăm sóc tốt gia súc đặc biệt là lúc giao mùa để nâng cao sức đề kháng đối với bệnh. Bổ sung các thuốc bổ, vitamin, khoáng vào thức ăn: Han-Goodway, Bcomplex, ADE, Hanmix-VK9…
- Định kỳ 6 tháng/lần kiểm tra máu đàn bò, phát hiện bò bệnh, cách ly điều trị.
𝟵. 𝗧𝗿𝗶̣ 𝗯𝗲̣̂𝗻𝗵
Để điều trị bệnh biên trùng có hiệu quả cao nên dùng phác đồ như sau: Rivanol liều lượng 0,2 – 0,4 g, cồn 900 liều lượng 60 ml, nước cất liều lượng 120 ml. Cách pha: Đổ Rivanol vào 120 ml nước cất, đun khoảng 880C quấy cho tan hết, lọc dung dịch bằng giấy lọc. Sau đó để nguội dung dịch xuống khoảng 500C thì pha thêm 60 ml cồn 900 vào ta được dung dịch thuốc dùng cho 1 liều điều trị. Khi nhiệt độ dung dịch thuốc xuống còn 38 – 400C thì tiến hành truyền chậm vào tĩnh mạch cho bò. Liệu trình: Dùng 2 – 3 liều dùng liên tục hoặc cách 1 ngày dùng thuốc 1 lần.
**Lưu ý: Bảo quản thuốc ở lọ thủy tinh màu trong chỗ tối, nếu phải truyền thuốc cho bò ở ngoài trời thì phải dùng giấy hoặc vật liệu tối màu bọc xung quanh chai thuốc. Trước khi dùng Riavanol phải tiêm trợ sức trợ lực bằng Cafein và Vitamin B1. Nuôi dưỡng và chăm sóc tốt trong thời gian điều trị, nên bổ sung các vitamin, khoáng chất để nâng cao sức đề kháng: B.Complex, ADE, để hạn chế bệnh lây lan, dùng: Hantox-200 phun trong và ngoài chuồng trại, xung quanh khu vực chăn thả, dùng Hantox-spray xịt ve trên bò định kỳ 2 – 3 tuần/lần.
Nếu bạn nghi ngờ bò của mình mắc phải bệnh biên trùng, việc quan trọng nhất là tìm sự hỗ trợ từ bác sĩ thú y hoặc chuyên gia chăn nuôi địa phương. Họ sẽ có kiến thức và kinh nghiệm để xác định và điều trị bệnh một cách hiệu quả.
DUNGCUNUOIBO.COM
Địa chỉ: 40 Lâm Thị Hố,P.Tân Chánh Hiệp, Quận 12,TP. Hồ Chí Minh.
Hotline: 0941 844 449
Email: dungcuthuyleanh@gmail.com

Xem thêm